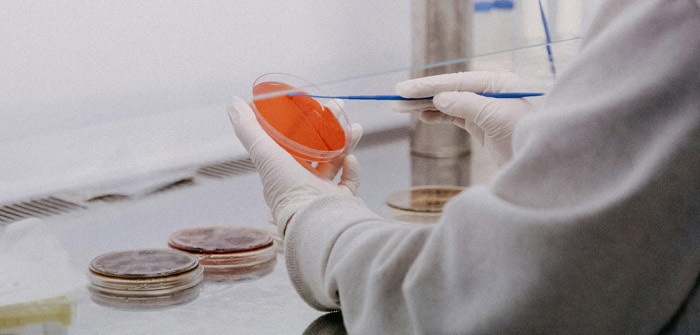
MOTS-c: A Mitochondrial-Derived Peptide with Expanding Frontiers in Research

Photo by Trnava University on Unsplash
The mitochondrial genome, once believed to serve a largely static and supportive role, has recently been revisited as a source of regulatory biomolecules. Among the mitochondrial-derived peptides identified in recent decades, MOTS-c (Mitochondrial Open Reading Frame of the 12S rRNA type-c) has emerged as an intriguing candidate for exploration in molecular, metabolic, and evolutionary biology. Discovered in 2015, MOTS-c is encoded within the 12S rRNA region of the mitochondrial genome and expressed as a 16-amino acid peptide. Unlike many nuclear-encoded proteins imported into mitochondria, MOTS-c arises directly from mitochondrial DNA, suggesting a unique signaling potential.
Investigations purport that MOTS-c might operate as a molecular bridge bet

 Cascade Business News
Cascade Business News
AlterNet
AlterNet 13 On Your Side
13 On Your Side Verywell Health
Verywell Health CNN Health
CNN Health The Conversation
The Conversation NBC News
NBC News NBC Connecticut
NBC Connecticut KSL NewsRadio
KSL NewsRadio Raw Story
Raw Story